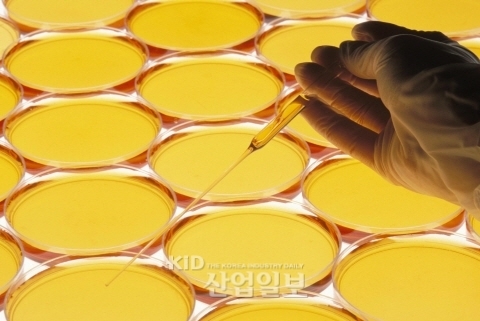
화학 산업 시장 아시아 ‘맹추격’

[산업일보]
2009년 세계 화학산업 매출은 약 2조 5250 억 달러 (1조 8710 억 유로) 였던 것으로 추정된다. 지난 10년간 EU는 화학 산업의 선도자로 확신했으나, 최근 아시아 국가들의 맹추격으로 그 입지가 줄어들었다.
CEFIC(유럽화학산업협회) 보고서에 따르면, 세계 화학 매출 부문에서 EU가 차지하는 비중은 지난 10년(1999 ~2009년)사이 약 8% 감소한 반면, 중국은 5.8%에서 22.2%로 비약적인 발전을 이룬것으로 나타났다.
아시아 다른 국가들 역시 동일한 기간 동안 13.1%에서 15.9%로 성장한 반면, EU, NAFTA, 일본 등 화학 산업의 핵심 역할을 해 온 국가들의 매출은 하락한 것으로 조사됐다.
2009년 중국 화학 시장 매출액은 약 6,353억 달러에 달했으며, 이는 1999 - 2009년 사이 7배 가량 증가한 것이다. 또한2009년 인도 매출액은 약 927억 달러로, 인도 역시 10년 사이 매출액이 3배 증가한 것으로 집계됐다.
화학 시장에서 세계 상위 35위에 속하는 기업들의 수익을 살펴보면, 2011년 1월부터 9월까지의 이들의 수익은 전년 동기 대비 평균적으로 약 17.8% 증가했고, 3 분기에만 약 11.3% 증가했다.
이들 중 아시아 기업들만을 분석해보면, 2011년 1월부터 9월까지는 전년 동기 대비 평균 약 18.6%를 기록했고, 3분기에만은 약 12.9% 늘었다.이는 전 세계 및 아시아 화학 기업들의 3분기 수익이 상반기에 비해 약화된 것으로 분석된다.
또한 이 두 자리 수 매출 성장을 할 수 있었던 주된 원인은 원자재 비용 증가에 따른 가격 인상에 따른 것으로, 실제 생산 규모는 평균 약 5% 증가에 그쳤다.

미국 경제와 아시아 산업의 영향
미국 경제 상황과 EU 경제 위기가 아시아 산업에 어떠한 영향을 미칠 것인지, 화학 산업의 경제지표는 무엇이며, 이는 올해와 향후 미래에 어떤 파급 효과를 낳을지에 관심이 모아지고 있다.
전세계 화학 산업에 영향을 미칠 것으로 예상되는 핵심 요인들에는 EU의 외채 위기, 미국의 침체된 경제, 중국의 여신규제, 그리고 원유가 상승을 들 수 있다. 앞의 3가지 요인들은 화학 수요에 영향을 미치는 한편, 마지막 원유가 상승은 기업 이윤에 영향을 미칠 것으로 전문가들은 예견하고 있다.
아시아에 위치하고 있는 대부분의 화학 기업들은 각 현지내 수요를 상대하고 있으며, 이들의 대다수 제품들 역시 내수 소비에 초점이 맞춰져 있다. 따라서 미국 경제상황과 EU 외채 위기가 아시아 화학 기업 운영에 큰 영향을 끼치지 않을 것이라는 견해를 내놓고 있다.
지속적인 엔화 강세로 인해, 대다수의 일본 업체들은 자신들의 생산시설을 다른 지역으로 이전할 것을 고려하고 있다. 생산시설을 자신들의 고객들과 가까운 곳으로 이전하는 것이 이들이 갖게 될 주요 과제가 될 것으로 보인다.
엔화 강세는 일본 화학 기업들에게 지난 몇 년간보다 비교적 낮은 가격에 미국 및 유럽 기업들을 인수할 수 있는 절호의 기회를 가져다주었다. 이들은 강력한 기술적 리더십을 발휘하고 있지만 미국 및 유럽 시장 접근이 용이하지 않았기 때문에, 특히 화학 부문에 특화된 미국과 유럽 기반의 화학 기업을 인수한다는 것은 세계적으로 주도하는 입지 구축을 가능케 할 것이라는 전망이다.
지난해 발생한 태국 홍수는 태국에서 화학에 대한 수요에 차질을 빚게 했으나, 2012년 2분기까지 다시 예전으로 회복할 것이라는 주장도 제기됐다.
이는 홍수 피해로 소비자들이 자신들의 제품을 교체하거나 수리함으로써, 건축용 도금이나 전기, 자동차 부품의 전기판을 위한 플라스틱에 대한 현지 수요가 작년대비 증가 할 것으로 예상되기 때문이다.
하지만 태국에 주둔하고 있는 주요 자동차 기업들이 이번 홍수로 큰 피해를 입음에 따라, 태국에 대한 의존도를 낮추기 위해 다른 지역으로 생산 시설 부분 이전를 고려하고 있다는 점은 태국 화학 산업에 장기적인 위협이 될 수 있다는 우려의 목소리도 나오고 있다.
아시아 화학 산업 세계화 영향
주요 세계 화학 기업들은 메가트렌드에 기반해 자신들의 장기적 성장 전략을 조정했다. 화학 기업들에게 세계화·저탄소 및 지속 가능성·화학 연료에 대한 의존도 감소, 작물 생산량 증가에 영향을 미칠 것으로 내다보고 있다.
세계 노령화 인구 증가로 안전 및 헬스케어에 대한 지출 증가하고 있으며, 기능성 성분 재료들에 대한 큰 관심으로 성장하는 추세다.
미국이나 유럽의 많은 기업들이 자신들의 생산 시설들을 아시아 지역으로 이전하고 있으며, 미국이나 유럽 기업들을 일본 및 한국 화학 기업들이 인수할 수 있는 기회를 가짐으로써, 세계화는 아시아 화학 산업에 긍정적인 영향을 끼쳤다.
또한 DuPont, BASF, Dow Chemicals, Bayer 등과 같은 세계적인 화학 기업들은 농약에 대한 R&D 투자를 강화시켰다. 그 일례로 2009년 DuPont사는 전체 R&D지출의 50%를 농업 부문에 할당한 것을 들 수 있다.
지속가능성에 대해 꾸준히 중점을 두는 것 역시 화학 기업들에게 두 가지의 기회를 주고 있다. 그 중 하나는 태양광 발전, 풍력 발전기, 바이오 연료 등과 같은 고성장 시장을 통한 기회이고, 나머지 하나는 생화학 및 바이오 플라스틱 시장의 성장을 꼽을 수 있다.
ASEAN 국가들은 지속 가능한 팜오일의 생산과 바이오메스의 활용을 통해 화석 연료 의존도를 줄이는 중요한 역할을 하고 있다. 많은 화학 기업들이 petroleum route 를 oleochemicals 로 부분적으로 대체시키는 경향을 보이고 있다.
핵심 고성장 부문 주목하라
전기 자동차, 태양광발전, 풍력발전기, 바이오 플라스틱, 그리고 바이오 화학에 사용되는 자재 및 화학 분야가 핵심 고성장 부문이다.
재생에너지 분야에 영향을 미쳐, 이는 결국 자재 및 화학물질 소비에도 영향을 미치는 핵심 요인은 바로 기준가격지원제도(feed-in-tariff, FIT)이다. 예를 들어, 독일과 이탈리아는 태양광발전에 대한 기준가격지원을 감축했으며, 이로 인해 2011년 수요가 상당수 하락했다.
한편 바이오플라스틱, 바이오화학, 바이오연료에 대한 지속적인 수요는 높은 원유가와 낮은 원자재가에 달려있다.






![[SIMTOS 2026] 12m 파이프도 흔들림 없이 자른다… 제이큐레이저, 대형 소재 레이저 가공 솔루션 선보여](http://pimg3.daara.co.kr/kidd/photo/2026/04/21/thumbs/thumb_168126_1776736031_53.jpg)
![[SIMTOS 2026] 판금 가공의 진화…보더레이저, '절단·용접·절곡' 통합 제어 체계 구축](http://pimg3.daara.co.kr/kidd/photo/2026/04/21/thumbs/thumb_168126_1776737078_53.jpg)




![[기고] 전쟁과 평화, 전쟁과 AX, 그리고 전시산업 썸네일 이미지](http://pimg3.daara.co.kr/kidd/photo/2026/04/15/thumbs/thumb_168126_1776241653_69.jpg)
![[Functional Fabric Fair 2026] 영원무역 친환경 충전재 '에코로프트' 글로벌 시장 수성 썸네일 이미지](http://pimg3.daara.co.kr/kidd/photo/2026/04/15/thumbs/thumb_168126_1776210638_3.jpg)





















![[SIMTOS 2026] 판금 가공의 진화…보더레이저, '절단·용접·절곡' 통합 제어 체계 구축](http://pimg3.daara.co.kr/kidd/photo/2026/04/21/thumbs/thumb_520390_1776737078_53.jpg)
![[SIMTOS 2026] 12m 파이프도 흔들림 없이 자른다… 제이큐레이저, 대형 소재 레이저 가공 솔루션 선보여](http://pimg3.daara.co.kr/kidd/photo/2026/04/21/thumbs/thumb_520390_1776736031_53.jpg)




